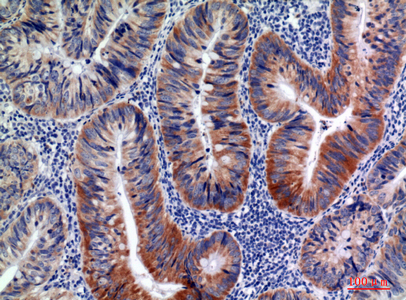
a00267 1 aicda primary antibodies ihc testing 1

Product Info Summary
| SKU: | A00267-1 |
|---|---|
| Size: | 100μl |
| Reactive Species: | Human, Mouse, Rat |
| Host: | Rabbit |
| Application: | ELISA, IF, IHC, WB |
Customers Who Bought This Also Bought
Product info
Product Name
Anti-AID AICDA Antibody
SKU/Catalog Number
A00267-1
Size
100μl
Form
Liquid
Description
Boster Bio Anti-AID AICDA Antibody catalog # A00267-1. Tested in WB, IHC, IF, ELISA applications. This antibody reacts with Human, Mouse, Rat.
Storage & Handling
Store at -20°C for one year. For short term storage and frequent use, store at 4°C for up to one month. Avoid repeated freeze-thaw cycles.
Cite This Product
Anti-AID AICDA Antibody (Boster Biological Technology, Pleasanton CA, USA, Catalog # A00267-1)
Host
Rabbit
Contents
Liquid in PBS containing 50% glycerol, 0.5% stabilizing protein and 0.02% sodium azide.
*This antibody is supplied in a stabilized formulation.
Compatibility with conjugation reactions depends on the chemistry of the conjugation method used.
For conjugation methods that are not compatible with the stabilizing components present in this formulation, a carrier-free antibody format is required.
Clonality
Polyclonal
Isotype
IgG
Immunogen
The antiserum was produced against synthesized peptide derived from the Internal region of human AICDA. AA range:81-130
Reactive Species
A00267-1 is reactive to AICDA in Human, Mouse, Rat
Observed Molecular Weight
39 kDa
Calculated molecular weight
24.0 kDa
Antibody Validation
Boster validates all antibodies on WB, IHC, ICC, Immunofluorescence, and ELISA with known positive control and negative samples to ensure specificity and high affinity, including thorough antibody incubations.
Application & Images
Applications
A00267-1 is guaranteed for ELISA, IF, IHC, WB Boster Guarantee
Recommend Dilution
WB 1:500-1:2000
IHC: 1:100-1:300
ELISA 1:10000
IF 1:50-200
Validation Images & Assay Conditions
Click image to see more details
Immunohistochemical analysis of paraffin-embedded human-colon-cancer, antibody was diluted at 1:100

Click image to see more details
Western Blot analysis of Hela, HepG2 cells using AID Polyclonal Antibody. Secondary antibody was diluted at 1:20000
Specific Publications For Anti-AID AICDA Antibody (A00267-1)
Loading publications
Recommended Resources
Here are featured tools and databases that you might find useful.
- Boster's Pathways Library
- Protein Databases
- Bioscience Research Protocol Resources
- Data Processing & Analysis Software
- Photo Editing Software
- Scientific Literature Resources
- Research Paper Management Tools
- Molecular Biology Software
- Primer Design Tools
- Bioinformatics Tools
- Phylogenetic Tree Analysis
Customer Reviews
Have you used Anti-AID AICDA Antibody?
Share your experimental results or join a short interview to earn up to $1,000 in product credits or other rewards.
0 Reviews For Anti-AID AICDA Antibody
Customer Q&As
Have a question?
Find answers in Q&As, reviews.
Can't find your answer?
Submit your question
5 Customer Q&As for Anti-AID AICDA Antibody
Question
Would anti-AID antibody A00267-1 work for IHC with chorionic villus?
Verified Customer
Verified customer
Asked: 2019-12-27
Answer
According to the expression profile of chorionic villus, AICDA is highly expressed in chorionic villus. So, it is likely that anti-AID antibody A00267-1 will work for IHC with chorionic villus.
Boster Scientific Support
Answered: 2019-12-27
Question
We are currently using anti-AID antibody A00267-1 for rat tissue, and we are happy with the WB results. The species of reactivity given in the datasheet says human, mouse, rat. Is it possible that the antibody can work on feline tissues as well?
W. Carter
Verified customer
Asked: 2018-06-20
Answer
The anti-AID antibody (A00267-1) has not been tested for cross reactivity specifically with feline tissues, but there is a good chance of cross reactivity. We have an innovator award program that if you test this antibody and show it works in feline you can get your next antibody for free. Please contact me if I can help you with anything.
Boster Scientific Support
Answered: 2018-06-20
Question
We appreciate helping with my inquiry over the phone. Here are the WB image, lot number and protocol we used for chorionic villus using anti-AID antibody A00267-1. Let me know if you need anything else.
L. Parker
Verified customer
Asked: 2016-09-26
Answer
We appreciate the data. You have provided everything we needed. Our lab team are working to resolve your inquiry as quickly as possible, and we appreciate your patience and understanding! Please let me know if there is anything you need in the meantime.
Boster Scientific Support
Answered: 2016-09-26
Question
Does anti-AID antibody A00267-1 work on zebrafish WB with b-cell?
T. Baker
Verified customer
Asked: 2014-06-10
Answer
Our lab technicians have not tested anti-AID antibody A00267-1 on zebrafish. You can run a BLAST between zebrafish and the immunogen sequence of anti-AID antibody A00267-1 to see if they may cross-react. If the sequence homology is close, then you can perform a pilot test. Keep in mind that since we have not validated zebrafish samples, this use of the antibody is not covered by our guarantee. However we have an innovator award program that if you test this antibody and show it works in zebrafish b-cell in WB, you can get your next antibody for free.
Boster Scientific Support
Answered: 2014-06-10
Question
Here is the WB image, lot number and protocol we used for chorionic villus using anti-AID antibody A00267-1. Please let me know if you require anything else.
N. Thomas
Verified customer
Asked: 2013-09-11
Answer
Thank you very much for the data. Our lab team are working to resolve this as quickly as possible, and we appreciate your patience and understanding! You have provided everything we needed. Please let me know if there is anything you need in the meantime.
Boster Scientific Support
Answered: 2013-09-11




